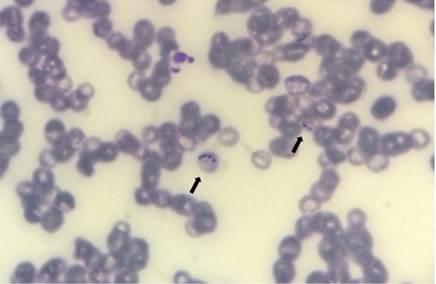
Inclus&otilde;es parasit&aacute;rias em hem&aacute;cias caracter&iacute;sticas de Babesia sp. (setas), observadas em esfrega&ccedil;o sangu&iacute;neo de bovino. Colora&ccedil;&atilde;o com pan&oacute;tico, aumento original 1000x.

Comparação entre métodos de avaliação direta para o diagnóstico de babesiose em bovinos
Comparison among direct evaluation methods of babesiosis diagnosis in cattle
Comparación entre los métodos de evaluación directa para el diagnóstico de babesiosis en bovinos
Comparação entre métodos de avaliação direta para o diagnóstico de babesiose em bovinos
Research, Society and Development, vol. 8, núm. 10, pp. 01-11, 2019
Universidade Federal de Itajubá

Este trabalho está sob uma Licença Internacional Creative Commons Atribuição 4.0.
Recepção: 06 Julho 2019
Revised: 05 Agosto 2019
Aprovação: 12 Agosto 2019
Publicado: 23 Agosto 2019
Resumo: O objetivo do presente estudo foi comparar três métodos de observação direta: esfregaço sanguíneo, esfregaço de ponta de orelha e capa leucoplaquetária, buscando o melhor método para o diagnóstico de Babesia spp. em bovinos. Foram utilizados 77 bovinos com suspeita de babesiose. Destes animais, foi realizada a coleta de sangue em veia jugular e ponta de orelha. Após obtenção das amostras, foram confeccionados os esfregaços sanguíneos e capa leucoplaquetária com material proveniente da jugular e esfregaço de ponta de orelha com material proveniente da perfuração da ponta de orelha. Dos 77 animais, 14,30% (n=11) foram encontradas inclusões em pelo menos um dos três métodos avaliados. Dos animais positivos, 36,35% (n=4) foram positivos apenas no esfregaço sanguíneo e o esfregaço de ponta de orelha sozinho não foi capaz de diagnosticar a enfermidade em nenhum dos animais. O coeficiente de concordância obtido no teste kappa mostrou fraca conciliação entre o método de observação pelo esfregaço de sangue de ponta de orelha considerado padrão ouro pela literatura, com esfregaço sanguíneo (.= 0,18) e com a capa leucoplaquetária (. = -0,12). A sensibilidade e especificidade do esfregaço sanguíneo foi de 40% e 100% e capa leucoplaquetária obteve 25% e 62%, respectivamente. O esfregaço sanguíneo com sangue obtido da jugular, mostrou-se o método com melhores resultados, quando comparado às demais técnicas, para o diagnóstico de babesiose em bovinos.
Palavras-chave: Hemoparasitas, Esfregaço sanguíneo, Tristeza Parasitária Bovina.
Abstract: The objective of the present study was to compare three methods of direct observation: blood smear, ear tip smear and leucoplatelet cover, searching for the best method for the diagnosis of Babesia spp. in cattle. Seventy-seven bovines with suspected babesiosis were used. From these animals, blood was collected in jugular vein and ear tip. After obtaining the samples, the blood smears and the leucoplaquetary layer were made with material from the jugular and smear of the ear tip with material from the perforation of the ear tip. Of the 77 animals, 14,30% (n = 11) inclusions were found in at least one of the three evaluated methods. Of the positive animals, 36.35% (n = 4) were positive only in the blood smear and the ear tip smear alone was not able to diagnose the disease in any of the animals. The concordance coefficient obtained in the kappa test showed a poor reconciliation between the blood smear observation method, considered gold standard in the literature, with blood smear (k = 0.18) and with the leucoplatelet layer (k = -0, 12). The sensitivity and specificity of the blood smear was 40% and 100% and the leucoplatelet layer obtained 25% and 62%, respectively. The blood smear with blood obtained from the jugular was the method with the best results when compared to the other techniques for the diagnosis of babesiosis in cattle.
Keywords: Hemoparasites, Blood smear, Bovine Parasitic Sadness.
Resumen: El objetivo del presente estudio fue comparar tres métodos de observación directa: frotis sanguíneo, frotis de punta de oreja y capa leucoplaquetaria, buscando el mejor método para el diagnóstico de Babesia spp. en bovinos. Se utilizaron 77 bovinos con sospechosos de babesiosis. De estos animales, se realizó la recolección de sangre en vena yugular y punta de oreja. Después de la obtención de las muestras, se confeccionaron los frotis sanguíneos y capa leucoplaquetaria con material proveniente de la yugular y frotis de punta de oreja con material proveniente de la perforación de la punta de oreja. Dos 77 animales, 14, 30% (n = 11) se encontraron inclusiones en al menos uno de los tres métodos evaluados. De los animales positivos, 36,35% (n = 4) fueron positivos sólo en el frotis sanguíneo y el frotis de punta de oreja solo no fue capaz de diagnosticar la enfermedad en ninguno de los animales. El coeficiente de concordancia obtenido en la prueba kappa mostró una débil conciliación entre el método de observación por el frotis de sangre de punta de oreja considerado patrón oro por la literatura, con frotis sanguíneo (k = 0,18) y con la capa leucoplaquetaria (k = -0,12). La sensibilidad y especificidad del frotis sanguíneo fue del 40% y 100% y la capa leucoplaquetaria obtuvo el 25% y el 62%, respectivamente. El frotis sanguíneo con sangre obtenida de la yugular, se mostró el método con mejores resultados, cuando comparado a las demás técnicas, para el diagnóstico de babesiosis en bovinos.
Palabras clave: Hemoparasitas, Frotis sanguíneo, Tristeza Parasitaria Bovina.
1. Introdução
A bovinocultura apresenta grande destaque na economia brasileira, de forma que o Brasil possui o segundo maior rebanho bovino do mundo, sendo responsável por 15,4% da produção global de carne bovina e 35 bilhões de litros de leite ao ano (IBGE, 2016).
As hemoparasitoses são enfermidades que representam aspectos limitantes ao crescimento da bovinocultura mundial, sendo a tristeza parasitária bovina (TPB), doença infecciosa e parasitária que mais gera prejuízos ao rebanho mundial. A mesma é transmitida pelo carrapato Rhipicephalus microplus, que tem como agentes etiológicos a Babesia spp. e Anaplasma spp. (Uribe, 2017).
Almeida et al. (2006) em um estudo realizado na região sul do Brasil, abrangendo aproximadamente 2.630.000 cabeças de gado, observaram que as perdas econômicas causadas pela TPB foram cerca de 6.220 cabeças por ano, totalizando um prejuízo de R$ 3.732.000,00. Já, Grisi, Massard, Moya-Borba & Pereira (2002) descreveram que os prejuízos causados pela TPB podem chegar a 500 milhões de dólares ao ano.
Guglielmone et al. (1999) observaram que a maior parte das perdas econômicas (62%) decorrentes da babesiose ocorreu pela morte e tratamento dos bovinos doentes, seguido de gastos com controle de ectoparasitas, medicamentos, testes para diagnóstico e contratação de médicos veterinários. Dessa forma, o diagnóstico e tratamento precoce seriam fundamentais para minimizar os prejuízos.
O diagnóstico da babesiose e anaplasmose bovina pode ser realizado por técnicas de biologia molecular como a Reação em cadeia da polimerase (PCR), testes sorológicos como o Imunofluorescência Indireta (Romero et al., 2016) e Imunoensaio Enzimático (ELISA) (Eichenberger et al., 2017).
Entretanto, os métodos citados acima, são de alto custo, demandando grande aparato laboratorial, sendo muitas vezes inviáveis para a realização em pequenas propriedades rurais. Dessa forma, métodos diretos como a observação dos protozoários em esfregaço sanguíneo, capa leucoplaquetária e esfregaço de ponta de orelha, seriam técnicas de suma importância, pois além de apresentarem baixo custo, podem ser realizados pelo veterinário a campo, otimizando o diagnóstico de hemoparasitoses em bovinos (Stobbe, Chaplin, Paiva, Araújo & Silva, 1988).
De acordo com Osaki et al. (2002) e Santos (2013) as hemácias parasitadas se tornam pouco flexíveis e são retidas por mais tempo na luz dos vasos de menor calibre, dessa forma, os eritrócitos parasitados são direcionados ao endotélio capilar, tornando o esfregaço de sangue de ponta de orelha o método padrão ouro para o diagnóstico. Bock, Jackson, De vos e Jorgensen (2004) e Kocan, De la fuente, Blouin, Coetzee & Ewing (2010) também apontam a observação direta em lâmina confeccionada com sangue da ponta de orelha de animais em fase aguda da infecção, como o melhor método direto para o diagnóstico de TPB.
Farias (1995) aponta que na fase aguda da doença ocorre a presença em grande quantidade de parasitas vivos no sangue, sendo os mesmos facilmente visualizados nos eritrócitos bovinos, por meio do esfregaço sanguíneo obtido de coletas da veia jugular.
A capa leucoplaquetária é obtida após a centrifugação do sangue com (ácido etilenodiamino tetra-acético (EDTA). Esta camada se localiza entre o compactado de hemácias e plasma, sendo composta por células nucleadas, plaquetas e até mesmo eritrócitos (Thrall, Weiser, Allison, & Campbell, 2015). Por conter as células alvo de hemoparasitas, a confecção e análise do esfregaço da capa leucoplaquetária, é bastante utilizada pelos médicos veterinários na visualização de hemoparasitas (Harrus & Waner, 2011).
Devido a grande incidência de TPB no rebanho bovino mundial, levando a inúmeros prejuízos econômicos que poderiam ser evitados com o diagnóstico precoce da enfermidade, o objetivo do presente estudo, foi comparar três métodos de observação direta: esfregaço sanguíneo, esfregaço de ponta de orelha e capa leucoplaquetária, buscando o melhor método para o diagnóstico de Babesia spp. em bovinos .
2. Materiais e métodos
Com a aprovação do Comitê de Ética no Uso de Animais da Universidade Federal do Espírito Santo, (CEUA – nº 25/2018), foram utilizados 77 bovinos, com raça, idade e sexo distintos, provenientes de propriedades localizadas nos municípios de Vargem Alegre em Minas Gerais, Alegre e Itapemirim no Espírito Santo, com suspeita de TPB.
As coletas foram realizadas em diferentes horários do dia. Para a confecção do esfregaço de ponta de orelha, foi realizado a perfuração do local, longe dos vasos sanguíneos mais calibrosos, sendo adicionada uma gota em lâmina de microscopia e realizado o esfregaço. Foi realizada higienização do local e tricotomia previa.
Para confecção do esfregaço de sangue da jugular, capa leucoplaquetária e hemograma, as amostras sanguíneas foram obtidas por punção da veia jugular em sistema de coleta a vácuo utilizando tubos com EDTA. Os tubos com EDTA foram acondicionados em caixa de isopor com gelo, e encaminhados ao Laboratório de Patologia Clínica do Hospital Veterinário. Todas as análises hematológicas foram realizadas de acordo com o preconizado por Thrall et al. (2015).
As amostras de sangue ao chegarem no laboratório, foram colocadas no homogeneizador Modelo MC II (DELLTA®) durante aproximadamente cinco minutos. Após este tempo as mesmas foram destinadas ao contador hematológico automatizado (Mindray® BC – 2800 Vet®) e posteriormente eram confeccionados os esfregaços sanguíneos.
Para a obtenção da capa leucoplaquetária, a separação dos constituintes sólidos do sangue foi realizada a centrifugação do sangue a 2000 gpm (giros por minuto) por cinco minutos em centrífuga de tubos (CELM®). Com o auxílio de pipetas, parte da capa leucoplaquetária foi coletada e depositada em lâmina para realização do squash.
As lâminas de esfregaço sanguíneo de ponta de orelha e jugular, assim como as lâminas confeccionadas com a capa leucocitária, foram fixadas em metanol e coradas por corante tipo panótico (Laborclin®). As leituras foram realizadas em microscópio óptico (Olympus CX41®), no aumento de 1000x, buscando por inclusões em hemácias sugestivas de Babesia spp. As avaliações foram realizadas sempre por um observador experiente e conferidas por um segundo avaliador, ambos médicos veterinários residentes.
Os dados foram tabulados, submetidos a análise de estatística descritiva, e posteriormente analisados pelo teste de Fisher. Posteriormente, foi calculada a sensibilidade, especificidade e coeficiente de concordância kappa. Todas as análises foram realizadas no programa estatístico GraphPad Prism 5.0®, a 5% de significância, considerando o teste de ponta de orelha como padrão ouro.
3.
A análise das 77 amostras de sangue dos bovinos apontou 14,30% dos animais (n=11) como positivos para babesiose. Assim, como demostrado na imagem (Figura 1), foram observadas inclusões sugestivas de Babesia sp. em eritrócitos, na avaliação por microscopia de lâminas com esfregaço sanguíneo.
Figura 1-
Inclusões parasitárias em hemácias características de Babesia sp. (setas), observadas em esfregaço sanguíneo de bovino. Coloração com panótico, aumento original 1000x.
Próprio autor.
O diagrama foi utilizado com intuito de organizar as informações e dados obtidos na pesquisa,facilitando o entendimento dos resultados (Figura 2), sendo que dos animais positivos(n=11), 36,37%(n=4)foram positivos apenas no esfregaço sanguíneo obtido de amostra sanguínea da jugular,9,09%(n=1)foi positivo apenas na capa leucoplaquetária e 54,54% (n=6),foram diagnosticados por associação entre as técnicas.

Figura 2 -
Resultados em Diagrama de Venn para métodos diagnósticosrealizados.
No entanto, o esfregaço de ponta de orelha sozinho não foi capaz de diagnosticar a enfermidade em nenhum dos animais. Resultado próximo ocorreu com Vasconcelos (2010) em pesquisa realizada com cães, em que se diagnosticou apenas 1,6% dos animais por meio do método direto em esfregaço de sangue periférico retirados da ponta de orelha ou coxins, entretanto, foram visualizados os piroplasmas nos esfregaços de sangue total desses cães.
Valente (2014) diagnosticou uma pequena parcela dos animais através dos métodos diretos. Dos 93 cães utilizados, apenas 12,9%, foram tidos como positivos na pesquisa parasitológica direta em franja de esfregaço sanguíneo, capa leucoplaquetária e esfregaço de sangue obtido da ponta de orelha, além de outras técnicas. Ocorreu positividade maior em esfregaço sanguíneo periférico (ponta de orelha) (5,1%), seguido da capa leucoplaquetária (2,2 %) e apenas 1,1% em franja de sangue obtido de punção da veia jugular, resultado diferente do obtido neste trabalho, onde maior positividade ocorreu no esfregaço sanguíneo obtidos da veia jugular.
Leal, Moraes, Barbosa & Lopes (2015) ao associar a técnica de observação em esfregaço sanguíneo com a realização da capa leucoplaquetária, identificou a presença da Babesia canis vogeli em 6,86% dos cães, indicando que a junção agregou na obtenção dos resultados. Porém, apenas 18,18 % dos animais apresentaram-se positivos tanto capa leucoplaquetária como no esfregaço de sangue total e apenas 9,09 % por associação das técnicas.
Entretanto, como apresentado na Tabela 1:

Próprio autor
O coeficiente de concordância obtido no presente trabalho, por meio do teste kappa, mostrou fraca conciliação entre o método de observação pelo esfregaço de sangue obtido na ponta de orelha, considerado nesta pesquisa como padrão ouro, com o esfregaço sanguíneo coletado na veia jugular (k= 0,18) e também com a capa leucoplaquetária (k = -0,12).
O longo intervalo de confiança e o valor de p observado indicam fraca associação entre os métodos, porém, acredita-se que os resultados encontrados foram ao acaso e o mesmo não deve ser generalizado para uma população. Além disso, o fato de o teste padrão ouro ter apresentado resultados inferiores as demais técnicas influenciou nos valores de sensibilidade e especificidade.
Outras intercorrências podem ser responsáveis pelos resultados obtidos, tais como o número de de animais avaliados, o número de animais positivos, assim como a ausência de um grupo controle utilizando a técnica da reação em cadeia da polimerase (PCR) como padrão ouro para o diagnóstico.
Valente (2014) comparou as técnicas de diagnóstico direto com os resultados do PCR e concluiu que todos os positivos na técnica de observação direta, também eram positivos no PCR, o que demostra que quando realizado por profissionais qualificados, o diagnóstico direto obtido é confiável. Entretanto, houve alguns falsos negativos, fato que demostra que o PCR deve ser utilizado, quando houver suspeita clínica específica de babesiose aguda e os resultados das técnicas diretas forem negativos ou em fase de convalescência da doença.
Cassini et al. (2011) por sua vez, diagnosticaram 21,6% dos animais avaliados em seu estudo como positivos no PCR e apenas 6,5% desses, foram considerados parasitados por métodos diretos. Desse modo, os resultados apresentados indicam que o método de observação direta em esfregaço diagnostica uma parcela dos animais, mas subestima a real ocorrência da enfermidade.
Além dos fatores já citados acima, o curso da doença na qual os animais foram avaliados, assim como o grau de infecção, e o momento da coleta do material analisado, podem ter influenciados nos resultados.
Isso ocorre, pois, a sensibilidade dos testes diretos é geralmente maior na fase aguda da doença, além desses animais apresentarem picos febris no final do dia, estando esses fatores estritamente relacionados a parasitemia no sangue e a observação dos protozoários (Bohm, Leisewitz, Thompson, & Schoeman, 2006).
Corroborando a isso, alguns bovinos apresentavam sinais clínicos clássicos da enfermidade e ao analisar os esfregaços não foram observadas inclusões sugestivas de hemoparasitoses, o que pode ser explicado pela coleta do material ter ocorrido em diversos momentos do dia e não nos picos febris ao final do dia.
Além disso, o contato do sangue utilizado para realizar os esfregaços de sangue obtido da jugular e capa leucoplaquetária com o EDTA e o fato das amostras terem sido armazenadas sob refrigeração, também pode ser um fator de considerável interferência nos resultados obtidos. Uma vez que, tais condições contribuem para uma menor visualização dos agentes etiológicos, tento em vista o desprendimento da inclusão devido ao contato com o anticoagulante (Otranto et al., 2011; Leal, Flausino & Lopes, 2012; Thrall et al., 2015).
4. Conclusões
A realização do esfregaço sanguíneo, mostrou-se o método com melhores resultados, quando comparado às demais técnicas, para o diagnóstico de babesiose em bovinos na rotina dos médicos veterinários. Como próximo passo, sugere-se a realização de estudo acrescido de outros métodos de diagnóstico como o PCR, sobretudo em suspeita de infecções subclínicas e crônicas.
Referências
Almeida, M. B, Tortelli, F. P., Correa, B. R., Ferreira, J. L. M., Soares, M. P., Farias, N.A. R., Correa, F. R., & Schild, A. L. (2006). Tristeza parasitária bovina na região sul do Rio Grande do Sul: estudo retrospectivo de 1978-2005. Pesquisa Veterinária Brasileira. v.26, n.4, p.237-242.
Bock, R., Jackson, L., De vos, A., & Jorgensen, W. (2004). Babesiosis of cattle. Parasitology, v. 129, n.7, p. 247-269.
Bohm, M., Leisewitz, A.L., Thompson, P.N., & Schoeman, J.P. (2006). Capillary and venous Babesia canis rossi parasitaemias and their association with outcome of infection and circulatory compromise. Veterinary Parasitology, v. 141, p. 18–29.
Cassini, R., Marcer, F., Di regalbono, A.F., Cancrini, G., Gabrielli, S., Morettic, A., Galuppi, R., Tampieri, M.P., & Pietrobelli, M. (2011). New insights into the epidemiology of bovine piroplasmoses in Italy. Veterinary Parasitology, v.184, n.1, p. 77-82.
Eichenberger, R. M., Štefanić, S., Naucke, T. J., Šarkūnas, M., Zamokas, G., Grimm, F., & Deplazes, P. (2017). An ELISA for the early diagnosis of acute canine babesiosis detecting circulating antigen of large Babesia spp. Veterinary Parasitology, v.243, p.162–168.
Farias N.A.R. (1995). Diagnóstico e Controle da Tristeza Parasitária Bovina. Editora Agropecuária: Guaíba, p.80.
Grisi, L., Massard, C. L., Moya-Borba, G.E., & Pereira, J. B. (2002). Impacto econômico das principais ectoparasitoses em bovinos no Brasil. A Hora Veterinária, v.125, p.8-10.
Guglielmone, A. A., Aguirre, D.H., Spath, E. J. A., Gaido, A. B., Mangold, A. J., & Ríos, L.G. (1999). Long-term study of incidence and financial loss due to cattle babesiosis in a Argentinian dairy farm. Preventive Veterinary Medicine, v.12, p.307–312.
Harrus, S. & Waner, T. (2011). Diagnosis of canine monocytotropic ehrlichiosis (Ehrlichia canis): An overview. 187(3), 292-296.
Instituto Brasileiro de Geografia e Estatística (IBGE): rebanho de bovinos tinha 218,23 milhões de cabeças em 2016. Acesso em 20 junho 2018, em http://www.beefpoint.com.br/ibge-rebanho-de-bovinos-tinha-21823-milhoes-de-cabecas-em-2016.
Kocan, K. M., De la fuente, J., Blouin, E. F., Coetzee, J. F., & Ewing, S. A. (2010). The natural history of Anaplasma marginale. Veterinary Parasitology, v. 167, n. 2-4; p. 95–107.
Leal, P.D.S., Flausino, W., & Lopes, C.W.G. (2012). Diagnóstico de infecções concomitantes por Neospora caninum, Babesia canis e Erhlichia spp. em canino adulto da raça Golden Retrivier - Relato de caso. Revista Brasileira de Medicina Veterinária, v.34, p.47-51.
Leal, P.D.S., Moraes, M.I.M.R., Barbosa, L.L.O., & Lopes, C.W.G. (2015). Infecção por hematozoários nos cães domésticos atendidos em serviço de saúde animal, Rio de Janeiro, Brasil. Revista Brasileira de Medicina Veterinária, v.37(Supl.1), p.55-62.
Osaki, S. C., Vidotto, O., Marana, E.R.M., Vidotto, M.C., Yoshihara, E., Pacheco, R.C., Igarashi, M., & Minho, A.P. (2002). Ocorrência de anticorpos anti Babesia bovis e estudo sobre a infecção natural em bovinos da raça nelore, na região de Umuarama, Paraná, Brasil. Revista Brasileira de Parasitologia Veterinária, v. 11, n. 2, p. 77-83.
Otranto, D., Dantas-Torres, F., Weigl, S., Latrofa, M.S., Stanneck, D., Decaprariis, D., & Baneth, G. (2011). Diagnosis of Hepatozoon canis in young dogs by cytology and PCR. Parasite and Vectors, v.4, n.55.
Romero-Salas, D., Mira, A., Mosqueda, J., García-Vázquez, Z., Hidalgo-Ruiz, M., Vela, N. A. O., & Schnittger, L. (2016). Molecular and serological detection of Babesia bovis- and Babesia bigemina-infection in bovines and water buffaloes raised jointly in an endemic field. Veterinary Parasitology, v.217, p.101–107.
Santos, G. B. (2013). Estudo epidemiológico da tristeza parasitária bovina em rebanhos dos municípios de petrolina e ouricuri, estado de pernambuco. 2013. 91 p. Dissertação (Mestrado em Ciência Animal) - Universidade Federal do Vale do São Francisco, UNIVASF, Campus Ciências Agrárias, Petrolina.
Stobbe, N.S., Chaplin, E.L., Paiva, M.G.S., Araújo, F.A.P., & Silva, N .R .S. (1998). Diagnóstico laboratorial de hemocitozoários através da distensão dc gota de coágulo dc sangue (Nota Prévia). In: CONGRESSO ESTADUAL DE MEDICINA VETERINÁRIA, 10., Porto Alegre, 1988. Anais. Porto Alegre, SOVERGS, p. 61.
Thrall, M. A., Weiser, G., Allison, R. W., & Campbell, T. W. (2015). Hematologia e Bioquímica Clínica Veterinária. 2. ed. Rio de Janeiro: Roca.
Uribe, J. A. Z. (2017). Chega de Tristeza! Temperatura retal no monitoramento da tristeza parasitária bovina - uma experiência pratica. Revista Leite Integral, v.101, p. 66 – 74.
Valente, P.C.L.G. (2014). Avaliação de métodos parasitológicos, sorológicos e moleculares no diagnóstico das hemoparasitoses caninas no Estado de Minas Gerais. Dissertação apresentada à Universidade Federal de Minas Gerais, Escola de Veterinária. UFMG - Escola de Veterinária, Belo Horizonte, MG.
Vasconcelos, M. F. (2010). Estudo da infecção por Babesia spp.em cães da região periurbana de Brasília, Distrito Federal. 85 f. Dissertação (Mestrado). Faculdade de Agronomia e Medicina Veterinária, Universidade de Brasília, Distrito Federal.
Porcentagem de contribuição de cada autor no manuscrito
Lorena Silveira de Almeida – 35%
Larissa Marchiori Sena – 20%
Graziela Barioni – 20%
Théo Matos Arantes Moraes – 15%
Ronaldo Eugênio de Oliveira – 10%
